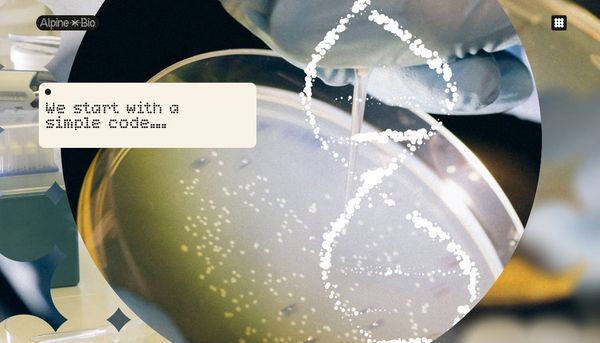

Newsletter
Join the Community
Subscribe to our newsletter for the latest news and updates
Alpine Bio is a plant genetics company transforming plants into the world's most regenerative biofactories
Make Your AI SaaS Product in a weekend! The complete Next.js boilerplate for building profitable SaaS, with auth, payments, i18n, newsletter, dashboard, blog, docs, blocks, themes, SEO and more.

The Membership Operating System